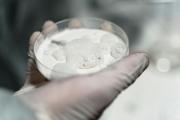
Ecuador decomisó 214 toneladas de droga en 2025, pero bajó frente a 2024

Seguridad
30 de diciembre de 2025 Página 1

Rubén Patricio G. S., Bryan Paúl G. S. y Santiago Rafael C. S. recibieron 40 años de prisión por el asesinato de un hombre ocurrido el 12 de mayo de 2024 en la avenida 9 de Octubre, según informó la Fiscalía.40 años de prisión por brutal asesinato en EcuadorLa víctima... + más
Contaminación plástica amenaza a toda la biodiversidad del Ecuador, revela estudio nacional | El Diario
Cinco detenidos por un asesinato en la avenida Juan Tanca Marengo, Guayaquil, son procesados | El Comercio

Christian Eduardo M. F., fue sentenciado a cuarenta años de privación de libertad como autor directo del asesinato de su prima política y el esposo de esta. La pena se dictó el 29 de diciembre de 2025 en Rumiñahui, provincia de Pichincha, Ecuador. Lo señalaron como autor... + más
Píllaro honra la memoria de Rumiñahui | El Heraldo
Cae alias 'Care Loco', presunto integrante de Los Lobos, en Rumiñahui; este es el delito que se investiga | El Comercio

El nombre de Roberto Carlos Álvarez Vera, conocido como alias ‘El Gerente‘, volvió al centro del debate nacional tras el anuncio del presidente Daniel Noboa sobre su traslado a Ecuador. Se trata del presunto líder de los Comandos de la Frontera, organización criminal... + más
Fiscalía solicita nueva audiencia para alias 'El Gerente' en caso Comandos de la Frontera | El Comercio

El Gobierno, a través del ministro del Interior, John Reimberg, difundió un video de alias ‘El Gerente’, supuesto cabecilla del grupo criminal Comandos de la Frontera, en la cárcel del Encuentro, en Santa Elena.La difusión del video de alias ‘El Gerente’ en la... + más
Detenciones que marcaron el mapa criminal durante el 2025 | El Diario
Fiscalía solicita nueva audiencia para alias 'El Gerente' en caso Comandos de la Frontera | El Comercio

Personal policial verificó un homicidio con el hallazgo de una persona fallecida por heridas causadas con cuchillo este lunes 29 de diciembre de 2025 a las 07h15 en la calle 9 de julio, atrás del cementerio del cantón Olmedo, provincia de Manabí, Ecuador. La víctima... + más
Manta es la ciudad más violenta de Manabí en el 2025. En este otro cantón se ha registrado un solo crimen | El Diario
Sentenciado a 40 años de prisión por doble asesinato de sus primos políticos en Rumiñahui | El Diario

El Gobierno de Ecuador confirmó este lunes la extradición desde Emiratos Árabes Unidos de Roberto Carlos Álvarez, alias “Gerente”, identificado como líder del grupo armado organizado Comandos de la Frontera, para que enfrente a la justicia ecuatoriana por su presunta... + más
Fiscalía solicita nueva audiencia para alias 'El Gerente' en caso Comandos de la Frontera | El Comercio
¿Quién es alias 'El Gerente, el líder de Comandos de la Frontera acusado por el asesinato de 11 militares en Ecuador? | El Comercio

La Policía capturó en Quito al segundo más buscado de Ecuador por defraudación tributaria millonaria este lunes 29 de diciembre de 2025; el ministro del Interior, John Reimberg, dio detalles del cometimiento del supuesto delito y la detención.La captura del segundo más... + más
Capturan en Quito al segundo más buscado del país por defraudación tributaria. Deuda supera los USD 9 millones | El Mercurio
En Quito la Navidad cambió, pero mantiene su esencia | El Comercio

La Fiscalía General del Estado confirmó que la audiencia de vinculación de Roberto Carlos Álvarez Vera, alias ‘El Gerente’, se realizará el 5 de enero de 2026. La medida responde a la nulidad de la audiencia previa en el caso de lavado de activos.Fiscalía solicita... + más
¿Quién es alias 'El Gerente, el líder de Comandos de la Frontera acusado por el asesinato de 11 militares en Ecuador? | El Comercio

Una operación militar en el cantón Playas, provincia de Guayas, terminó con la detención de dos hombres por el delito de tráfico de combustible. Esto tras recibir una alerta por baja de presión en el poliducto, con el objetivo de proteger la infraestructura... + más
Operativo militar frenó el robo de combustible en el poliducto en Playas | El Comercio
Decomisan camión y 1.000 galones de combustible en el poliducto de Quinindé | El Diario

El control de los pasos fronterizos del Ecuador se mantiene bajo supervisión del Ejército, como parte de las acciones de seguridad dispuestas por el Gobierno. Las fuentes del Ministerio de Defensa, este lunes, 29 de diciembre de 2025, confirmaron que varios pasos fronterizos... + más
Cierre de pasos fronterizos genera rechazo | El Mercurio
Fronteras bajo llave: seguridad, economías criminales y el dilema del control en Ecuador | El Diario

Un tribunal penal de Pichincha sentenció este lunes 29 de diciembre a Christian Eduardo M. F. a 40 años de prisión. Se trata de la pena máxima agravada, por el asesinato de su prima política y el esposo de esta en el sector Fajardo, cantón Rumiñahui, provincia de... + más
La sentencia escrita definirá el grado de responsabilidad de los militares en el caso Las Malvinas | El Comercio
Justicia y límites al uso de la fuerza en el caso de Las Malvinas | El Comercio
La Secretaría de Comunicación de la Presidencia difundió el balance anual y subrayó que las fuerzas del orden “asestaron golpes contundentes al narcotráfico“. El Ejecutivo sostuvo que estas acciones provocaron una afectación económica superior a 6,435 millones de... + más
Policía halla tres toneladas de droga en una finca de municipio costero de Ecuador | El Comercio
La Policía decomisa al menos tres toneladas de droga en el sector Pile de Montecristi, Manabí | El Diario

Jorge Gabela, general retirado y excomandante de la Fuerza Aérea (FAE), murió un 29 de diciembre de 2010, 10 días después de ser baleado, en su domicilio; a los 15 años de su fallecimiento, su viuda, Patricia Ochoa, insiste en la “más perversa impunidad”.Jorge Gabela:... + más
Jorge Glas denunció tortura y persecución política durante audiencia de hábeas corpus | El Diario
(En vivo) Jorge Glas comparece de forma telemática en audiencia de habeas corpus | El Comercio

Juan Carlos Delgado, de aproximadamente 28 años y conocido como “El Negro“, fue asesinado la noche del domingo 28 de diciembre de 2025 en el sector Urbirrios 1 de Manta. Esto tras un ataque sicario atribuido por autoridades a disputas territoriales entre bandas delictivas.... + más
Manta es la ciudad más violenta de Manabí en el 2025. En este otro cantón se ha registrado un solo crimen | El Diario
Cuatro detenidos, con fusiles, durante persecución policial tras un asesinato en Manta | El Diario

El presidente Daniel Noboa, a través del Decreto Ejecutivo 268, aprobó las zonas de seguridad del Estado de Frontera y las Áreas Reservadas de Seguridad que estarán bajo el control de las Fuerzas Armadas, este lunes 29 de diciembre de 2025.Las zonas de seguridad del Estado... + más
Asamblea autoriza la licencia a Daniel Noboa por 18 días para asuntos personales | El Comercio
Daniel Noboa se pronuncia sobre la situación del Presidente del Consejo de la Judicatura | El Comercio

La Comisión Interamericana de Derechos Humanos (CIDH) otorgó medidas cautelares en beneficio de 26 personas desaparecidas y seis mujeres buscadoras en el marco de un estado de excepción respecto de Ecuador, el 24 de diciembre de 2025.La solicitud de medidas cautelares para... + más
CIDH exige búsqueda de 26 personas desaparecidas en operativos militares | El Diario
Glas no saldrá a un hospital; juez niega hábeas corpus | El Comercio

El ministro del Interior, John Reimberg, anunció la madrugada de este martes 30 de diciembre la llegada de Roberto Carlos Álvarez, alias ‘El Gerente’, a Ecuador, luego de ser extraditado desde Emiratos Árabes Unidos. ‘El Gerente’ es el presunto cabecilla de los... + más
Fiscalía solicita nueva audiencia para alias 'El Gerente' en caso Comandos de la Frontera | El Comercio
¿Quién es alias 'El Gerente, el líder de Comandos de la Frontera acusado por el asesinato de 11 militares en Ecuador? | El Comercio

La Policía Nacional anunció el envío de cerca de 50 uniformados adicionales al cantón Puerto López, en la provincia de Manabí, para fortalecer la seguridad. Esta acción se decidió en una mesa de seguridad convocada por la gobernadora Aurora Valle, en respuesta a una... + más
Qué pasó en Puerto López. Nueve muertos en 48 horas | El Comercio
Violentos ataques armados motivan la visita de John Reimberg, ministro del Interior, a Puerto López | El Diario

La defensa del exvicepresidente Jorge Glas aguarda que, a más tardar a finales de enero, la Corte Interamericana de Derechos Humanos (Corte DH) se pronuncie sobre la solicitud de ampliación de las medidas provisionales otorgadas en octubre, con el fin de que se ordene su... + más
Jorge Glas denunció tortura y persecución política durante audiencia de hábeas corpus | El Diario
Glas no saldrá a un hospital; juez niega hábeas corpus | El Comercio

La circulación de un video que muestra a hombres armados disparando en distintos sectores de San Lorenzo, en la provincia de Esmeraldas, reactivó la alerta de seguridad en esta zona fronteriza. El Ministerio de Defensa confirmó este lunes 29 de diciembre de 2025 la... + más
Esmeraldas: tres asesinatos en un solo día sacuden la provincia norteña | El Diario
La AMT realiza operativos de tránsito en Quito este 23 de diciembre | El Comercio

Autoridades revisaron los documentos entregados para la ejecución del evento. (Foto cortesía) Los organizadores del “Diablada Fest” mantuvieron una reunión de coordinación con Vinicio Constante, intendente de Policía, con el propósito de planificar y socializar la... + más
Presentación de la Diablada Pillareña | El Heraldo
Seis días de fiesta en Píllaro: conoce el cronograma completo de la Diablada Pillareña 2026 | El Diario

La pareja agredida fue enviada a una revisión médica. (Foto El Heraldo) Un escándalo en la vía pública se registró en la intersección de las calles Carlos Torolem y José Rudecindo Ingavelez, en el sector Huachi Belén. La Policía Nacional atendió el suceso. En el... + más
Deterioro de la vía a la cárcel Bellavista se agrava tras las primeras lluvias en Santo Domingo | El Diario
Feriado de fin de año: estado actualizado de las vías en Ecuador | El Comercio

Richard Intriago, de 18 años, fue detenido el domingo 28 de diciembre de 2025 alrededor de las 18:00 en el sector La Unión Popular de El Carmen, provincia de Manabí, Ecuador, por tenencia de drogas. Personal de las Fuerzas Armadas entregó al sospechoso al distrito policial... + más
La guerra que perdimos: por qué las políticas de control de drogas están fracasando | El Diario
Choque entre motocicletas deja dos heridos de gravedad en la vía El Carmen-Pedernales | El Diario

La desaparición de Alina Micaela Pihuave Narváez, exreina del cantón Puerto López, mantiene en alerta a sus familiares y a las autoridades de Manabí. La joven fue vista por última vez el 27 de diciembre de 2025 y, desde entonces, no se tiene información sobre su... + más
Qué pasó en Puerto López. Nueve muertos en 48 horas | El Comercio
Lo que se sabe de la desaparición de Alina Pihuave, exreina de Puerto López | El Comercio
Notibol. Desde 2006. Central de Noticias.
Notibol es un agregador informático de noticias y no es responsable del contenido de los enlaces a los sitios externos que generan las noticias.
Acerca de Notibol | Contacto | Política de Privacidad | Descargo de Responsabilidad